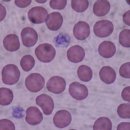
건강정보③ - 혈액, 혈액형의 개념, 혈액과 관련된 질병, 이미지

카페검색 본문
카페글 본문
-
혈액형 판정 실험/페이퍼 퓨지(10111안다연) 2024.10.21해당카페글 미리보기
특히 Rh-와 Rh+의 조합) 불일치 시 태아에게 면역학적 문제가 생길 수 있습니다. 이를 예방하기 위해 산모와 태아의 혈액형을 판정하고 예방 조치를 취합니다. 3. 출생 및 친자 확인: 친자 확인이나 가계도 연구에서 혈액형은 중요한 지표입니다. 부모와...
-
Rh(-)혈액형과 스페인의 바스크족 2021.09.05해당카페글 미리보기
특성 중 하나가 Rh(-)혈액형입니다 우리나라에서는 이를 Rh 마이너스라고 말하는데 외국에선 Rh 네거티브로 말하고, 이렇게...입니다. 재미있는 것은 유럽에서 바스크 지역 쪽으로 가까이 갈수록 Rh(-)의 비율이 높아진다는 사실입니다 대개 백인들의 15%...
-
혈액형(ABO,Rh) 어떤 것이 있는가 2012.09.04해당카페글 미리보기
식 혈액형의 "Rh"는 붉은털 원숭이의 영어 머리글자를 따서 붙여진 이름입니다. 붉은털원숭이의 혈액을 토끼에게 주사하면 토끼의 혈청에 붉은털원숭이의 혈구에 대한 항체가 생깁니다. Rh 응집원을 가지면 Rh+, 안가지면 Rh-입니다. 따라서 Rh+형 혈액...
-
Rh혈액형 응집반응 과정, 유전자상호작용, 2권93쪽에 대한 질문이요! 2015.02.17해당카페글 미리보기
원숭이가 동일하게 가지고 있다면 Rh(-)형인 사람도 응집반응이 일어나서 실험에 혼동을 줄 여지가 있지 않은것인가요? 사람과...유전자 상호작용에서 주어진 관계를 보고 어떤 비율로 표현형이 나오는지는 잘 알겠는데 표현형의 분리비를 보고 유전자...
-
나라별 혈액형 분포 비율 2010.07.21해당카페글 미리보기
분포 비율 나라별 ABO 혈액형 분포 (인구 평균)[5] 국가 O A B AB 대한민국 28% 32% 30% 10% 독일 41% 43% 11% 5% 러시아 33% 36% 23% 8% 미국 45% 40% 11% 4% 베트남 42% 22% 30% 5% 스위스 40% 50% 7% 3% 스페인 38% 47% 10% 5% 영국 47% 42% 9% 3%...
-
혈액형 비율 2013.09.18해당카페글 미리보기
한국인의 ABO Rh 혈액형 분포; A형(34%), B형(27%), O형(28%), AB형(11%), Rh음성(0.3%), Rh양성(99.7%) 입니다. 추게에 글쓰신분 도와드리고싶다........ 쾌유를 바랄게여ㅜㅜ
-
[과학과 신앙] (31) 페루의 숨겨진 아픔 2025.11.27해당카페글 미리보기
아니라 Rh식 혈액형, MN식 혈액형 등 무려 31가지 방법이 있다. 혈액형은 국가별·인종별 차이를 보이는데 우리나라 국민의 경우 A형(34%)이 가장 많고 그 다음은 O형(28%)·B형(27%)·AB형(11%) 순이다. 중국은 전 국민의 48%가 O형이며 미국의 경우 백인...
-
호주 역사상 가장 많은 헌혈을 한 사람 2025.12.17해당카페글 미리보기
임산부의 혈액형이 Rh 음성이고 태아가 Rh 양성이라면, 임산부는 항체를 생성해 태아의 '외래' 혈액 세포를 파괴할 수 있는 거야. 해리슨의 혈장에는 희귀한 D 항체가 들어 있었고, 과학자들은 이 혈장의 희귀 항체를 이용해 약물을 만들었는데, 이 약물로...
-
[영화속 의학 이야기] 모두에게 수혈 가능한 Rh-O형 사람 간 직접 수혈은 위험 2015.05.25해당카페글 미리보기
맥스의 혈액형이 Rh-O형인 것은 어떻게 알았는지 궁금합니다. 영화는 영화일 뿐, 너무 개연성을 분석하는 것도 예의가...맥스: 분노의 도로’의 핵심 아이콘이었습니다. 지구의 70%도 물이고 신체의 70%도 물입니다. 지구와 우리 몸의 물 비율이 놀랍도록...
-
건강정보③ - 혈액, 혈액형의 개념, 혈액과 관련된 질병, 2017.07.14해당카페글 미리보기
비율 더피 Fy(a-b-) 흑인에서 높은 비율 켈 Jsa 흑인에서 높은 비율 Rh V 흑인에서 높은 비율 키드 JK(a-b-) 필리핀인과 하와...N, S, s 흑인에서만 드물게 항원이 발견(Su와 헨쇼 유전자) 혈액형의 인구분포 출혈과 혈액응고 지혈의 중요성 척추동물이...




![[영화속 의학 이야기] 모두에게 수혈 가능한 Rh-O형 사람 간 직접 수혈은 위험 이미지](https://search2.kakaocdn.net/argon/130x130_85_c/Kn4svjPFzPF)